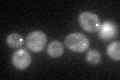
YHR111W
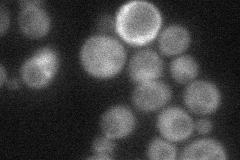
YHR111W

View description
Protein that activates Urm1p before its conjugation to proteins (urmylation); one target is the thioredoxin peroxidase Ahp1p, suggesting a role of urmylation in the oxidative stress response
Localization:
Intensity:
Fold change:
Significance:
-
C’ GFP library in SD
cytosol:punctate37.58 -
N' NOP1pr-GFP in SD

cytosol106.201 -
N' TEF2pr-mCherry in SD

cytosol134.215 -
N' NATIVEpr-GFP in SD
cytosol41.8616 -
N' TEF2pr-VC and Cyto-VN in SD

cytosol56.9787 -
C’ GFP library in SD+DTT

cytosol.punctate45.51.21No -
C’ GFP library in SD+H2O2

cytosol.punctate54.811.45Yes -
C’ GFP library in Starvation Media

punctateN/AN/AYes -
C’ GFP library on the background of Pup2-DaMP

cytosol:punctate -
C’ GFP library on the background of CCT mutant

cytosol:punctate40.73261.08347No
